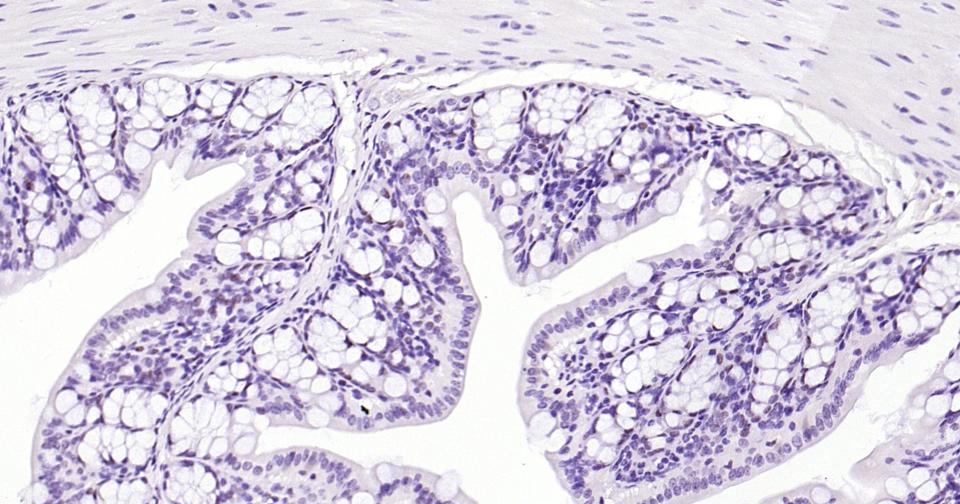
产品细节图片2

相关产品推荐更多 >
万千商家帮你免费找货
0 人在求购买到急需产品
- 详细信息
- 文献和实验
- 技术资料
- 应用范围:
产品信息以Bioss网站为准
- 规格:
50ul/100ul/25ul
| 规格: | 50ul | 产品价格: | ¥1400.0 |
|---|---|---|---|
| 规格: | 100ul | 产品价格: | ¥2500.0 |
| 规格: | 25ul | 产品价格: | ¥800.0 |
| 产品编号 | bsm-60001R |
| 英文名称 | EZH2 Recombinant Rabbit mAb |
| 中文名称 | 抑癌蛋白EZH2重组兔单抗 |
| 英文别名 | Enhancer of zeste homolog 2; Enx1h; MGC9169; Enhancer of zeste 2; ENX-1; ENX 1; ENX1; EZH 2; EZH2_HUMAN; Histone-lysine N-methyltransferase EZH2; KMT6A; Lysine N-methyltransferase 6; Enhancer of zeste homolog 2(Drosophila); Enhancer of zeste, Drosophila, homolog 2; KMT 6; KMT6A; KMT6; WVS2. |
| 产品应用 | WB=1:500-2000, IHC-P=1:50-200, IHC-F=1:50-200, IF=1:50-200 Not yet tested in other applications. |
| 交叉反应 | Human, Mouse, Rat |
| 抗体来源 | Rabbit |
| 免疫原 | KLH conjugated synthetic peptide derived from human EZH2 |
| 亚型 | IgG |
| 性状 | Liquid |
| 纯化方法 | affinity purified by Protein A |
| 克隆类型 | Recombinant |
| 理论分子量 | 82 kDa |
| 浓度 | 1mg/ml |
| 储存液 | 0.01M TBS (pH7.4) with 1% BSA, 0.02% Proclin300 and 50% Glycerol. |
| 研究领域 | Epigenetics and Nuclear Signaling > Chromatin Remodeling > Polycomb Silencing > PRC2 |
| 亚基 | Binds ATRX via the SET domain (Probable). Component of the PRC2/EED-EZH2 complex, which includes EED, EZH2, SUZ12, RBBP4 and RBBP7 and possibly AEBP2. The minimum components required for methyltransferase activity of the PRC2/EED-EZH2 complex are EED, EZH2 and SUZ12. The PRC2 complex may also interact with DNMT1, DNMT3A, DNMT3B and PHF1 via the EZH2 subunit and with SIRT1 via the SUZ12 subunit. Interacts with HDAC1 and HDAC2. Interacts with PRAME. |
| 亚细胞定位 | Nucleus. |
| 组织特异性 | xpressed in many tissues. Overexpressed in numerous tumor types including carcinomas of the breast, colon, larynx, lymphoma and testis. |
| 翻译后修饰 | Phosphorylated by AKT1. Phosphorylation by AKT1 reduces methyltransferase activity. Phosphorylation at Thr-345 by CDK1 and CDK2 promotes maintenance of H3K27me3 levels at EZH2-target loci, thus leading to epigenetic gene silencing. |
| 相似性 | Belongs to the histone-lysine methyltransferase family. EZ subfamily. Contains 1 CXC domain. Contains 1 SET domain. |
| 功能 | olycomb group (PcG) protein. Catalytic subunit of the PRC2/EED-EZH2 complex, which methylates 'Lys-9' (H3K9me) and 'Lys-27' (H3K27me) of histone H3, leading to transcriptional repression of the affected target gene. Able to mono-, di- and trimethylate 'Lys-27' of histone H3 to form H3K27me1, H3K27me2 and H3K27me3, respectively. Compared to EZH2-containing complexes, it is more abundant in embryonic stem cells and plays a major role in forming H3K27me3, which is required for embryonic stem cell identity and proper differentiation. The PRC2/EED-EZH2 complex may also serve as a recruiting platform for DNA methyltransferases, thereby linking two epigenetic repression systems. Genes repressed by the PRC2/EED-EZH2 complex include HOXC8, HOXA9, MYT1, CDKN2A and retinoic acid target genes. EZH2 can also methylate non-histone proteins such as the transcription factor GATA4. |
| 保存条件 | Shipped at 4℃. Store at -20℃ for one year. Avoid repeated freeze/thaw cycles. |
| 注意事项 | This product as supplied is intended for research use only, not for use in human, therapeutic or diagnostic applications. |
| 背景资料 | This gene encodes a member of the Polycomb-group (PcG) family. PcG family members form multimeric protein complexes, which are involved in maintaining the transcriptional repressive state of genes over successive cell generations. This protein associates with the embryonic ectoderm development protein, the VAV1 oncoprotein, and the X-linked nuclear protein. This protein may play a role in the hematopoietic and central nervous systems. Multiple alternatively splcied transcript variants encoding distinct isoforms have been identified for this gene. [provided by RefSeq, Feb 2011]. |
| 应用 | 推荐稀释比例 |
| {WB} | {1:500-2000} |
| {IHC-P} | {1:50-200} |
| {IHC-F} | {1:50-200} |
| {IF} | {1:50-200} |

风险提示:丁香通仅作为第三方平台,为商家信息发布提供平台空间。用户咨询产品时请注意保护个人信息及财产安全,合理判断,谨慎选购商品,商家和用户对交易行为负责。对于医疗器械类产品,请先查证核实企业经营资质和医疗器械产品注册证情况。
文献和实验[IF={{ 6.1 }}] {Zhao Wenzhi. et al. SOX4 accelerates intervertebral disc degeneration via EZH2/NRF2 pathway in response to mitochondrial ROS-dependent NLRP3 inflammasome activation in nucleus pulposus cells. J TRANSL MED. 2025 Dec;23(1):1-19} {IF,WB} {Rat}
[IF={{ 3.5 }}] {Di Wu. et al. Discovery of novel pyridone-benzamide derivatives possessing a 1-methyl-2-benzimidazolinone moiety as potent EZH2 inhibitors for the treatment of B-cell lymphomas. BIOORGAN MED CHEM. 2024 Apr;:117725} {WB} {Human}
到 PVDF 膜上,同时减少蛋白不必要降解,这对于最终获得清晰、可信结果也是需要考虑因素。抗体信息:1.ACC1, Recombinant Rabbit monoclonal IgG. HuaAn. HuaAn biotechnology , inc.2.ATGL, Mouse mAb IgG1, Cat#:RT1058. HuaAn biotechnology , inc.3.p-PERK(Thr981), Rabbit Polyclonal IgG primary antibodies, Cat
实际上将作为阴性对照使用。CST 推荐使用 Histone H3 (D2B12) XP® Rabbit mAb (ChIP Formulated) #4620。该抗体可检测与基因组中所有 DNA 序列结合的所有组蛋白 H3 类型(H3、H3.3、CENP-A)。因此,不管检测的位点活性状态如何,该抗体都能为 ChIP 实验提供通用的阳性对照。 阴性对照 阴性对照抗体(如正常兔 IgG)不能识别特异抗原表位,因此可用于检测非特异性结合。例如,如果阴性对照样品中的产物量等于特异
The OP9-DL1 System: Generation of T-Lymphocytes from Embryonic or Hematopoietic Stem Cells In Vitro
al. 2006b ). MATERIALS Reagents Anti-CD24 monoclonal antibody (mAb) (J11d clone) (for Protocol 3) Use either culture supernatant that contains anti-CD24 mAb or purified anti-CD24 mAb (see Step 55). BDPharmLyse (red blood cell lysing
技术资料暂无技术资料 索取技术资料










